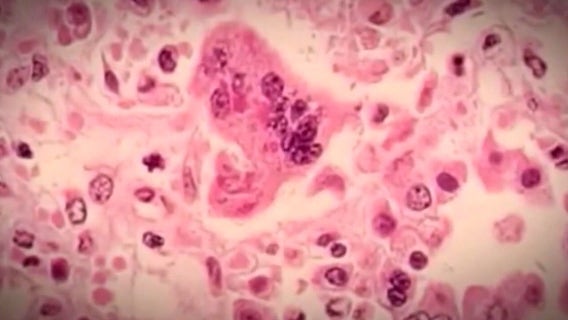
Measles in Michigan: 3 total cases reported by health officials

CDC dispatches team to Chicago as measles cases prompt concerns
As measles cases tick upward, the Chicago Department of Public Health, on Tuesday, confirmed three more cases of the disease at the city’s migrant shelter in Pilsen.
Paul Alexander, who lived in iron lung for most of his life, has died at 78
Paul Alexander has lived in the chamber for 70 years, and he went on to become a lawyer and author.
Single LSD dose provides lasting relief from anxiety, researchers find
MM120, an LSD formulation designed to treat generalized anxiety disorder, was recently granted a breakthrough therapy designation by the FDA.
Child flu vaccinations are at 19 percent in Michigan, say medical officials
Although flu season is already underway, with winter close to ending - it’s not too late for kids to get the vaccine.
Most US teens feel peaceful without smartphones, study finds
A recent Pew Center Research study delved into the relationship between teenagers and their smartphones.
Michigan reports first influenza-associated death in children as vaccine coverage dips
The child that died contracted influenza A(H1H1). It's one of 93 influenza-associated deaths in kids around the U.S.
FDA approves Wegovy to reduce heart attack and stroke risk
The U.S. Food and Drug Administration approved a label change that expands the use of the drug in Wegovy. It was previously approved to treat obesity.
Physicians union at Ascension St. John on verge of strike: 'We need staffing'
Members of the Greater Detroit Association of Emergency Physicians say they are prepared to take their fight to the picket line if things do not get better soon.
Daylight saving time: How springing forward could affect your health
Daylight Saving Time is this Sunday. “Springing Forward" can cause tiredness, but it can also impact your health.
Melatonin warning: ER visits for children accidentally eating supplements spike
Use of melatonin, which often comes in flavored, gummy form, has grown among U.S. adults – and so have emergency department visits for children accidentally ingesting them.
German man received 217 coronavirus vaccine shots over a 29-month period, study says
The individual from Magdeburg underwent the repeated jabs "deliberately and for private reasons" and against the recommendations of national health authorities, scientists say.
COVID-19 during pregnancy could cause health issues for babies, study suggests
Babies born to mothers who are infected with COVID-19 had “unusually high rates" of respiratory distress, a recent study from the journal Nature Communications, suggested.
Gas stoves will likely not be banned in the US anytime soon
It’s estimated that some 40 million U.S. homes have natural gas stoves. They’re often touted as being a more precise heating tool for cooking, but they can be pricey — and potentially harmful to both human health and the planet.
Allergies are starting earlier thanks to a mild winter
Allergies are going to be a bigger problem this spring and that means your asthma may feel worse too.
Man dies after consuming too much vitamin D as experts warn of risks: 'Cascade of problems'
Here's what to know about staying safe when taking supplements
Nearly 500 deaths per day from excessive drinking during COVID-19 pandemic: CDC report
Excessive drinking is associated with chronic dangers such as liver cancer, high blood pressure, stroke and heart disease.
Measles in Michigan: 3 total cases reported by health officials
Given the highly contagious nature of measles, medical and public health officials are raising concerns after three total cases were recently reported in southeast Michigan.
Birth control that will be sold over-the-counter begins shipping in the US: What to know
Opill, the first birth control pill approved in the U.S. for purchase by anyone, no prescription necessary, will be available in stores later this month. Here is what to know about the approved contraceptive.
Measles in Michigan: Health officials warn of 5 possible exposure locations
Five places in Southeast Michigan have been identified as possible measles exposure locations after two more cases of the illness were detected recently.
2 more measles cases detected in Michigan, Wayne and Washtenaw counties report
Both Wayne and Washtenaw County Health Departments are working closely with MDHHS to identify anyone who might've been exposed.